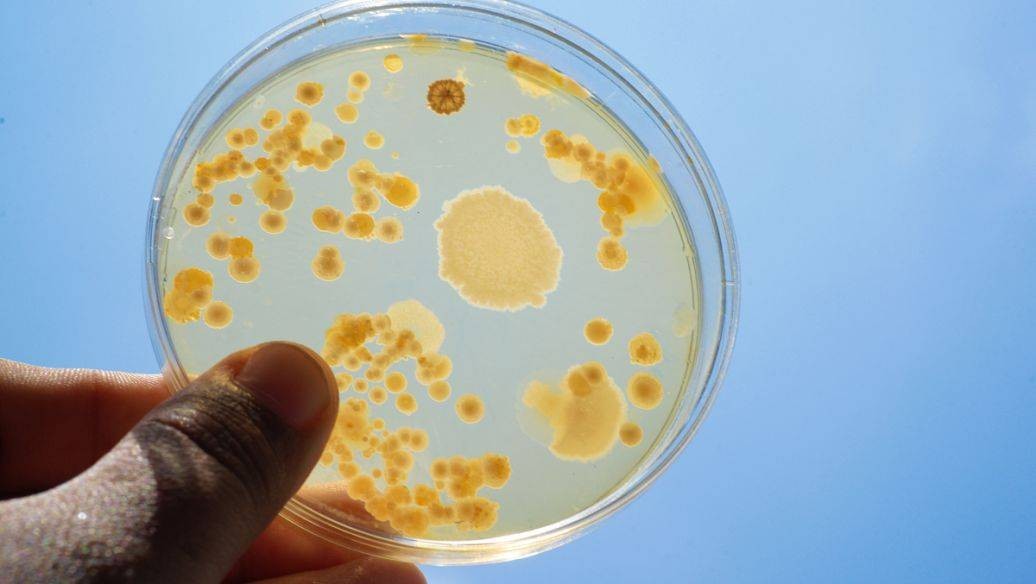

抗菌/抑菌产品检测要求
抗菌/抑菌产品检测要求涵盖理化指标、微生物指标、毒理学评价、抑菌性能及稳定性测试。依据GB 38456-2020、GB/T 19877-2026等标准,对洗手液、洗剂等日化品进行金黄色葡萄球菌、大肠杆菌等菌种测试。企业需确保产品符合消字号备案要求,通过CMA/CNAS资质检测,保障产品安全合规上市。
抗菌/抑菌产品检测要求涵盖理化指标、微生物指标、毒理学评价、抑菌性能及稳定性测试。依据GB 38456-2020、GB/T 19877-2026等标准,对洗手液、洗剂等日化品进行金黄色葡萄球菌、大肠杆菌等菌种测试。企业需确保产品符合消字号备案要求,通过CMA/CNAS资质检测,保障产品安全合规上市。

消毒剂检测标准汇总涵盖GB 27951-2021皮肤消毒剂、GB/T 26366-2021二氧化氯消毒剂等最新国标。涉及理化指标、杀灭微生物指标、毒理学安全性及稳定性测试。企业需依据《消毒技术规范》完成第一、二、三类消毒产品卫生安全评价,确保产品合规备案上市,规避监管风险。

食品功能验证有哪些?本文详解降糖、免疫调节、抗氧化等核心功能检测项目,涵盖体外实验、动物试验及人体试食三类验证方法。介绍检测流程、执行标准及数据解读要点,帮助食品企业科学评估产品功效,确保功能宣称合规,提供专业第三方功能评价服务参考依据。

全面解析塑料瓶、玻璃瓶、不锈钢瓶等各类瓶子的检测项目,涵盖GB 4806.7(塑料)、GB 4806.9(金属)、GB 4806.5(玻璃)中的总迁移量、重金属溶出、密封性能、跌落测试、堆码测试、耐温性能、标签标识等核心指标,帮助包装企业应对2026年市场监管抽检。

全面解析伞类产品检测要求,涵盖GB/T 23147晴雨伞国家标准中的抗风性能、拒水性能、防紫外线性能、伞骨抗风强度、开关耐久性、耐腐蚀性、伞面防雨性能等核心指标。结合2026年《晴雨伞特殊性能分级评价技术要求》团体标准,帮助企业提升产品质量分级与市场竞争力。

护目镜及防护面罩作为PPE个人防护装备,需通过光学性能、抗冲击性、耐腐蚀性、防雾性能、视野范围等核心检测项目。依据EN 166、ANSI Z87.1、GB 14866等国内外标准,解析实验室测试方法、合格判定标准及CE认证流程,帮助生产企业精准匹配产品用途与检测要求。

全面解析湿巾检测项目,涵盖GB/T 27728湿巾国家标准中的微生物限度、防腐剂有效性、重金属含量、pH值、可迁移荧光增白剂、含液量、横向抗张强度等核心指标,结合2025年国家监督抽查数据,帮助企业规避微生物超标、防腐剂违规等高频不合格风险。

全面解析卫生巾检测项目,涵盖GB/T 8939-2018《卫生巾(护垫)》中的全长偏差、吸水倍率、pH值、甲醛含量、可迁移性荧光物质、背胶剥离强度,以及GB 15979-2002《一次性使用卫生用品卫生标准》中的细菌菌落总数、真菌菌落总数、致病菌等微生物指标,帮助卫生巾企业应对2025年监督抽查。

家具检测项目涵盖物理机械性能、化学环保性能、阻燃性能、耐久性测试、结构安全等五大类。依据GB 18584、GB/T 3324、EN 16122、BIFMA X5.1等国内外标准,系统梳理办公家具、儿童家具、软体家具、木质家具等品类的核心检测项目与合格判定标准。

床垫检测项目依据GB 18584-2024《家具中有害物质限量》及QB/T 1952.2-2023《软体家具 弹簧软床垫》,涵盖甲醛释放量、TVOC、阻燃性能、弹簧耐久性、面料物理性能及结构安全,出具CMA/CNAS资质报告,支持电商平台入驻及招投标。

美妆工具涵盖化妆刷、粉扑、美妆蛋、睫毛夹等品类,检测项目包括微生物指标、重金属残留、刷毛脱落率、色牢度、致敏香料筛查等。依据GB 15979-2024一次性使用卫生用品卫生要求及ASTM D1234标准,解析美妆工具的核心检测要求与市场准入条件。

全面解析时尚首饰检测项目,涵盖GB 28480强制性国标中的铅、镉、镍释放量、六价铬、砷、汞等有害元素限量要求,以及儿童首饰增塑剂、可萃取重金属、标签标识等专项检测。结合欧盟REACH法规和美国加州65法案最新要求,依据2025年欧美市场召回案例数据,帮助企业规避重金属超标风险与市场准入障碍。
提交产品信息后,可优先安排需求沟通

扫码联系客服报价
广州
广州市黄埔区瑞和路3号首层火村商务中心大厦11楼A1101
深圳
深圳市坪山区碧岭街道碧岭社区坪山金碧路543号忠诚科技大厦801B
上海
上海市奉贤区星火开发区莲塘路251号8幢
芜湖
安徽省芜湖市镜湖区范罗山街道黄山中路金鼎大厦1411
四川
四川省遂宁市射洪市平安街道文化路412号
宁波
浙江省宁波高新区清逸路7号024幢201室
北京
北京市朝阳区太阳宫中路16号院1号楼
武汉
武汉市江夏区光谷科技港1A栋18楼1805